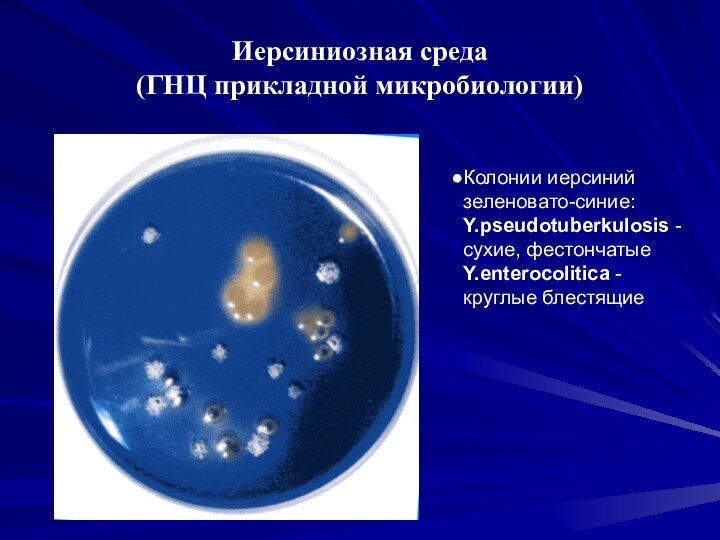

Колония в микробиологии это
Всегда жарко и душно
Карта памяти sdxc 128gb uhs ii
Сколько лет паше технику в 2025
Уха осетровая
Amazing butt
Подавать документы в 5 вузов
Как задонатить в ворлд танк блиц
Причины пробуждения азии кратко
Схема движения 55 маршрутки
Gagik tadevosyan mek mek
Поставить автосалон на комиссию
Позитивная ответственность примеры
Акб энерго отзывы
Колония в микробиологии это 115 фотографий